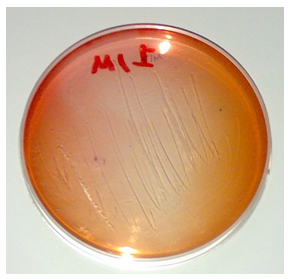
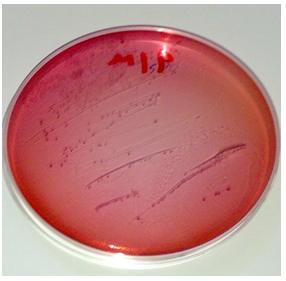
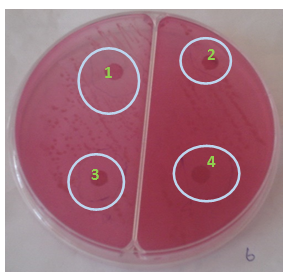
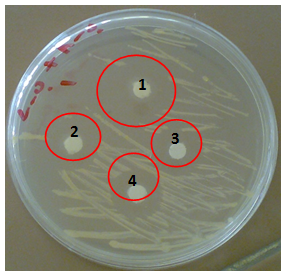

Journal of
eISSN: 2373-437X


Research Article Volume 7 Issue 3
Department of Chemistry, Faculty of Applied Science, Thamar University, Yemen
Correspondence: Asaad Mohammed A. Ataa, Department of Chemistry, Division of Biochemistry, Faculty of Applied Science, Thamar University, P.O.BOX. 87246, Thamar, Yemen, Tel 00962785504595
Received: May 27, 2019 | Published: June 7, 2019
Citation: Ataa AMA. Effect of YEMECIN antibiotic on bacteria gram positive Streptococcus mutans, Staphylococcus albus and gram negative E. coli, Salmonella typhi. J Microbiol Exp. 2019;7(3):150-154. DOI: 10.15406/jmen.2019.07.00254
Introduction and objective: This study aims to identify the effectiveness of YEMECIN antibiotic that has been recently discovered in Yemen and its impact on some Gram Positive bacteria (Streptococcus mutans, Staphylococcus albus) and some Gram Negative (E. coli, Salmonella typhi),which have been obtained pure in hospitals and others have been isolated at Laboratory . The organisms have been obtained as pure cultures from hospitals and laboratories.
Materials and methods: The study was conducted to validate the effectiveness of extracts and their effects on bacteria. The following microorganisms were employed in the study (Positive and Negative): Staphylococcus albus, Streptococcus mutans, Salmonella typhi, E.coli.
Results: The results of sensitivity screening, which were performed in the following ways: (CD-proliferation plates and confirmation way), showed the sensitivity of these microbes with rates ranging between (99%) for YEMECIN antibiotic to (36.2%) for Oxacillin with X antibiotics. While the less ones were antibiotics for Streptococcus mutans, Staphylococcus albus.
The inferences: The results showed the effectiveness of YEMECIN antibiotic with its quality in eliminating most microbes especially E.coli and less influence on Salmonella typhi and Staphylococcus albus.
Keywords: YEMECIN antibiotic, resistant, sensitivity, Escherichia coli, Salmonella typhi, Streptococcus mutans, Staphylococcus albus
Garlic is one amongst the edible plants that has generated a great deal of interest throughout human history as a medicinal panacea. A wide range of microorganisms including, bacteria, fungi, protozoa and viruses have been shown to be sensitive to crushed garlic preparations. Moreover, garlic has been reported to cut back blood lipids and to own metastatic tumour effects. Chemical Analyses of garlic cloves have unconcealed an uncommon concentration of sulfur-containing compounds (1-3%).1,2 search of the medical database at the National Library of Medicine in the USA reveals that garlic is top of the league for published research papers that cover a wide variety of disease conditions, the most prevalent of which are its significant antimicrobial properties.3 Products have created giant contributions to human health and well-being. the inexperienced pharmacy might become the bottom for the event of medicines by providing a pharmacophore that might be used for the event of the latest drug with novel mechanisms of action.4 Garlic (Allium sativum) could be a common spice used for seasoned and has been historically fashionable robust folkloric awareness. it's the edible bulb of lily family, Liliaceae. It contains aromatic sulfur based mostly compounds, that contribute to the characteristic odor and style. Antimicrobial activity of garlic is attributed to its key component Allicin.5 The YEMECIN antibiotic this is new antibiotic it’s discovery in Yemen which were this antibiotic showed effect of eliminating most microbes (bacteria and fungi) and that effect more than some antibiotic.6
Study objectives
Culture media
I attended all agricultural communities as instructed by the company processed and sterilized with a temperature of autoclaves 121°C and under pressure (15) lbs/Wang for a period of 15 minute.
Solutions and staining used
Distilled water; YEMECIN antibiotic, Sodium Hydroxide (NaOH); and Bromocresol Purple dye.
Sterilization
All work has been carried out under strict sterilization procedures and sterile conditions during the course of isolation, reclamation, bacteriological and dietary tests.
Devices and tools
Working methods
Sensitivity screening test for Streptococcus mutans, Staphylococcus albus, E.coli, Salmonella typhi bacteria.
Disk Diffusion
It is way in which we use the pre-wetted filter paper in the extracts of (YEMECIN) antibiotic.
Disk Diffusion
It's approach within which we tend to use the pre-wetted paper within the extracts of (YEMECIN) antibiotic.
The circle's area unit prepares that area unit wont to develop the microorganism mentioned earlier. Conjointly making ready the extracts of (YEMECIN) antibiotic and Pharmacy antibiotics to be placed within the clean, striated and day pipes. Then a precise quantity of paper that was fashioned within the form of tiny disks during a diameter starting from zero.5 cm; in every tube, there are associate extracts of (YEMECIN) antibiotic and Pharmacy antibiotics. The disks ought to be left within the tube for an amount between a 0.5 on hour to 2 hours to soak up a solvent quantity of (YEMECIN) antibiotic and Pharmacy antibiotics.7 When analytic microorganism, we tend to table the paper saturated with the extracts of (YEMECIN) antibiotic and Pharmacy antibiotics and place it in several places by sterilized extractor with alcohol and flame to put in on the surface by the sunshine pressure by forceps; all ought to be alone. When words, incubating the growth dishes on a temperature of 37°C and for an amount between (24-48) hours.
Confirmatory test to detect the inhibitory ability of the extract of (YEMECIN) antibiotic and Pharmacy antibiotics
This way is dove by pouring the extract of (YEMECIN) antibiotic and Pharmacy antibiotics on the growth after transplanting bacteria by planning to observe the inhibition. The way is the some way of (Disk-proliferation), but the difference lies in that after isolation, the process of pouring a certain amount of (YEMECIN) antibiotic and Pharmacy antibiotics on the growth disks and placing the dishes into the incubator to grow at a temperature of 37°C for a period, the results are recorded. All work has been carried out under strict sterilization procedures and sterile conditions during the course of isolation, reclamation, bacteriological and dietary tests.
The results refer to the sensitivity of YEMECIN antibiotic, Ampicillin antibiotic, Oxacillin antibiotic & X antibiotic, and their percentages. The results of the sensitivity examination state the sensitivity of those microbes for many of those extracts employed in this study with rates vary between (99%) for YEMECIN antibiotic, (81.5%) for Ampicillin antibiotic, and (67.3%) for Oxacillin antibiotic. (50%) for X antibiotic, everyone sort of Oxacillin with X antibiotics and (36.2%) for antibiotics. The variations will be seen through the sensitivity of YEMECIN and antibiotics will be seen that variation in sensitivity through numerous sorts of ID (Figures 1-9).
Figure 2 The inhibitory capacity of the extracts on, Staphylococcus aureus, method Confirmatory test.
Figure 4 The inhibitory capacity of the extracts on, Staphylococcus albus, method Confirmatory test.
Figure 6 The inhibitory capacity of the extracts on Staphylococcus albus, method Disk Diffusion.
(1)YEMECIN antibiotic, (2) P antibiotic, (3) X antibiotic,(4) X1 antibiotic. Zone of inhibition (1) 2.6 Cm, (2) 0.5 Cm, (3) 1.4 Cm, (4) 2.8 Cm.
Figure 7 The inhibitory capacity of the extracts on, E.coli, method Disk Diffusion. (1) YEMECIN antibiotic, (2) P antibiotic, (3) X antibiotic,(4) X1 antibiotic. Zone of inhibition (1) 3 Cm, (2) 1.8 Cm, (3)1.1 Cm, (4) 1.2 Cm.

Figure 8 Sensitive of Bacteria (YEMECIN and Antibiotics) (method of disks spread and confirmed test)
None.
Author declares that there is no conflict of interest.

©2019 Ataa. This is an open access article distributed under the terms of the, which permits unrestricted use, distribution, and build upon your work non-commercially.